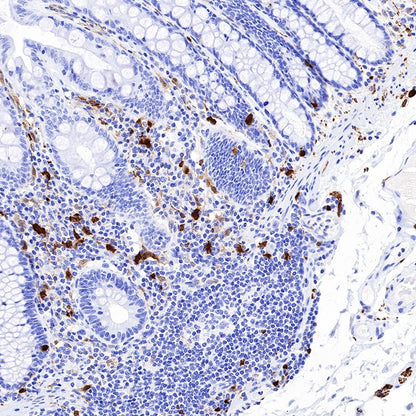

Product Specification
| Host |
Rabbit |
| Antigen |
S100B |
| Synonyms |
Protein S100-B,
S-100 protein beta chain |
| Immunogen |
Recombinant Protein |
| Location |
Cytoplasm, Nucleus |
| Accession |
P04271 |
| Clone Number |
SDT-093-108 |
| Antibody Type |
Rabbit mAb |
| Application |
WB, IHC-P, IF |
| Reactivity |
Hu, Ms, Rt |
| Purification |
Protein A |
| Concentration |
0.125 mg/ml |
| Physical Appearance |
Liquid |
| Storage Buffer |
PBS, 40% Glycerol, 0.05%BSA, 0.03% Proclin 300 |
| Stability & Storage |
12 months from date of receipt / reconstitution, -20 °C as supplied |
Dilution
| application |
dilution |
species |
| IHC-P |
1:2500 |
|
| WB |
1:500 |
|
| IF |
1:1250 |
|
Background
S100B is a Ca2+-binding protein, which is secreted from astrocytes. S100B is widely expressed in astrocytes, certain neuronal populations, Schwann cells, myeloid-derived cells, and a few other cell types. S100B is released in the extracellular space in response to glutamate, serotonin, TNF, IL-1β, beta-amyloid peptides, and lysophosphatidic acid. Extracellular S100B exerts both paracrine and autocrine effects on neurons and glia100, through RAGE, and possibly other receptors. The effect of S100B is concentration dependent and can be either trophic or toxic. In humans, high levels of extracellular S100B have been detected under various clinical conditions, for example, brain trauma, ischemia and neurodegenerative, and inflammatory and psychiatric diseases.